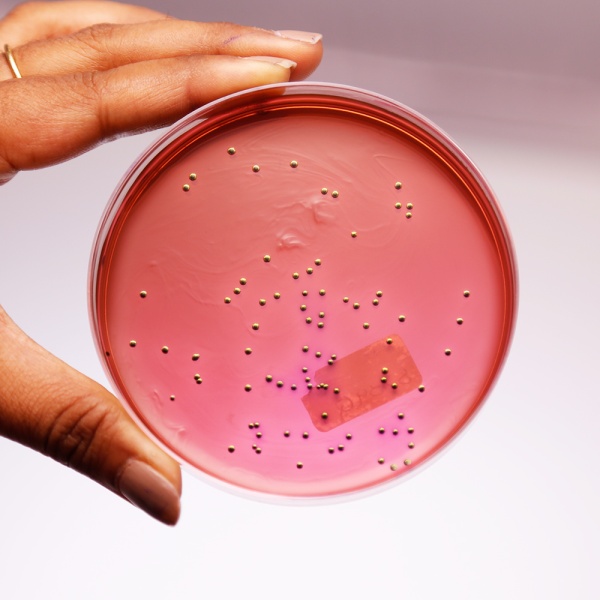
محیط کشت emb آگار
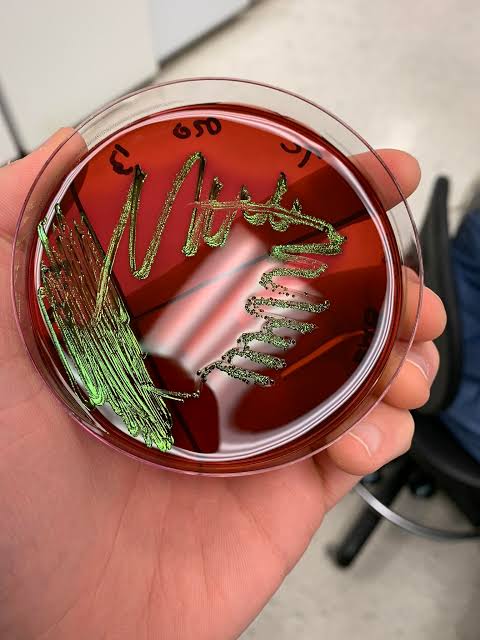
محیط کشت emb آگار مرک

در آزمایشگاههای میکروبیولوژی، برای تشخیص انواع باکتریها از محیط کشت های مخصوص استفاده میشود. یکی از مهمترین این محیطها، محیط کشت EMB آگار است.
این محیط یک ابزار بسیار ارزشمند برای تشخیص باکتریهای گرم منفی و مخصوصاً کلیفرمها و E.coli بهحساب میآید.
اگر در آزمایشگاه کنترل کیفیت صنایع غذایی، آب، داروسازی، محیطزیست یا بیمارستان فعالیت میکنید، تقریباً غیرممکن است با محیط کشت EMB ائوزین متیلن بلو اگار (Eosin Methylene Blue Agar) کار نکرده باشید.
بهخاطر همین اهمیت بالا، برندهای معتبر مثل Merck (مرک) این محیط کشت را با بالاترین کیفیت تولید میکنند.
شرکت ایدهآوران طب پیشتاز یکی از تأمینکنندگان رسمی محیطهای کشت و مواد میکروبی از برندهایی مثل Merck، Sigma، و USP در ایران است.
محیط کشت EMB آگار چیست؟
EMB Agar مخفف Eosin Methylene Blue Agar یا ائوزین متیلن بلو اگار میباشد.
این محیط یک محیط انتخابی – تفریقی است، یعنی:
۱.انتخابی (Selective)
چون رشد باکتریهای گرم مثبت را مهار میکند و باعث میشود فقط باکتریهای گرم منفی رشد کنند.
(به دلیل وجود رنگهای ائوزین Y و متیلن بلو)
۲.تفریقی (Differential)
یعنی میتواند بین انواع مختلف باکتریها تفاوت ایجاد کند.
مثلاً:
- E.coli → کلونی سبز فلزی
- باکتریهای تخمیرکننده لاکتوز → صورتی تا بنفش
- غیرتخمیرکننده لاکتوز → بیرنگ
همین ویژگیها باعث شده EMB یکی از بهترین محیطهای کشت برای شناسایی آلودگیهای آبی، غذایی، دارویی و محیطی باشد.
محیط کشت EMB آگار EMB Agar چیست محیط کشت Eosin Methylene Blue خرید EMB Agar Merck محیط کشت انتخابی گرم منفی محیط کشت افتراقی لاکتوز نمایندگی مرک مواد کشت میکروبی ایدهآوران طب پیشتاز
تشخیص اشرشیا کلی در EMB کلنی های فلزی سبز E.col محیط کشت انتخابی گرم منفی Enterobacteriaceae تفاوت مک کانکی و EMB ترکیبات محیط کشت EMB eosin Y و methylene blue agar محیط کشتهای برند مرک Merck اندیکاتور تخمیر لاکتوز محیط کشتهای آزمایشگاهی داروسازی
ترکیبات اصلی محیط کشت EMB آگار :
۱. لاکتوز : برای تشخیص باکتریهای تخمیرکننده
۲. ائوزین Y : بازدارنده گرم مثبت + ایجاد رنگ
۳. متیلن بلو : بازدارنده رشد گرم مثبت
۴. پپتون : مواد غذایی برای رشد باکتری
۵. آگار : جامدکننده محیط
ائوزین و متیلن بلو دقیقا همان موادی هستند که باعث تفاوت رنگ کلونیها میشوند.
EMB چه باکتریهایی را تشخیص میدهد؟
۱. باکتریهای تخمیرکننده لاکتوز (Lactose fermenters)
- E. coli
- Klebsiella
- Enterobacter
در این باکتریها اسید تولید میشود و با رنگهای محیط واکنش داده و کلونی صورتی تا بنفش میسازند.
۲.باکتریهای غیرتخمیرکننده لاکتوز
مثل:
- Salmonella
- Shigella
این باکتریها کلونی بیرنگ یا شفاف میسازند.
محیط کشت EMB آگار برای تشخیص باکتریهای گرممنفی محیط کشت EMB Agar برای شناسایی E.coli محیط کشت EMB مرک اصل از ایدهآوران طب پیشتاز بهترین محیط کشت انتخابی برای جداسازی اشرشیا کلی ترکیبات و طرز کار محیط کشت EMB Agar Merck
کاربرد محیط کشت EMB آگار :
۱.شناسایی کلیفرمها (Coliforms)
یکی از مهمترین کاربردهای EMB تشخیص آلودگیهای مدفوعی در آب و فاضلاب است.
۲. تشخیص قطعی E.coli
کلونی سبز–متالیک علامت مشخص E.coli است.
این ویژگی در تمام استانداردهای جهانی (APHA, EPA) استفاده میشود.
۳. کنترل کیفیت در صنایع غذایی
برای تشخیص آلودگی در شیر، لبنیات، گوشت، آب، نوشیدنی و مواد خام.
۴.کنترل کیفیت در صنایع آب و فاضلاب
طبق استاندارد تصفیه آب، EMB جزء محیطهای مرجع است.
۵. آزمایشگاههای داروسازی و میکروبیولوژی
برای ارزیابی آلودگیهای میکروبی در مواد اولیه، تجهیزات، هوا و آب WFI
محیط کشت EMB آگار مرک (MERCK) – بهترین انتخاب برای آزمایشگاهها :
شرکت Merck یکی از معتبرترین تولیدکنندگان محیط کشت در جهان است و EMB مرک ویژگیهای زیر را دارد:
- فرمول استاندارد مطابق APHA و FDA
- رنگدهی قوی و واضح
- تشخیص سریع E.coli
- کیفیت ثابت و قابل اعتماد برای تستهای QC
- مناسب صنایع غذایی، آب و داروسازی
اگر کیفیت محیط کشت برای شما مهم است، برند مرک بهترین انتخاب است.

خرید محیط کشت EMB آگار مرک از ایدهآوران طب پیشتاز :
شرکت ایدهآوران طب پیشتاز واردکننده مستقیم مواد آزمایشگاهی زیر است:
- محیط کشتهای Merck, Sigma-Aldrich,
- مواد شیمیایی آزمایشگاهی و دارویی
- مواد کنترل کیفیت میکروبی
- کیتهای تشخیصی تخصصی
مزایا:
✔️ اصالت کالا
✔️ تحویل سریع
✔️ امکان ثبت سفارش عمده
✔️ قیمت مناسب برای شرکتها و دانشگاهها
کشت ائوزین متیلن متیلن بلو e.coli محیط کشت مرک کشت بلاد محیط کشت emb آگار محیط کشت emb agar کلبسیلا روی محیط emb شیگلا روی محیط emb محیط کشت emb چه رنگی است گزارش کار محیط کشت emb کنترل کیفی محیط کشت emb طرز تهیه محیط کشت emb محیط کشت مرک
منابع :
- Atlas, R.M. Handbook of Microbiological Media. CRC Press.
- APHA Standard Methods for the Examination of Water and Wastewater.
- FDA Bacteriological Analytical Manual (BAM), Chapter for Coliforms and E.coli.
- Merck Millipore Technical Data Sheet – EMB Agar.
- European Pharmacopoeia 2.6.13, Microbiological Examination
دیدگاه خود را بنویسید